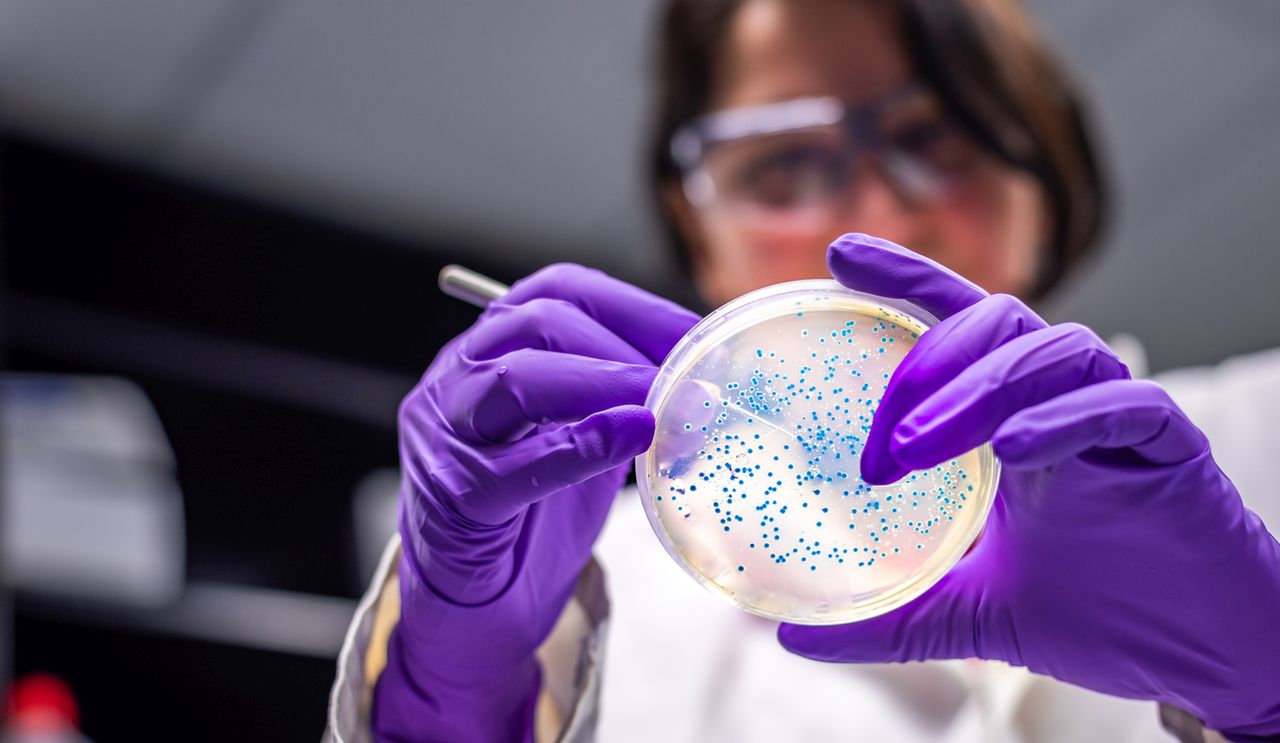

Е дна шеста от потвърдените бактериални инфекции са резистентни към антибиотици, а нивата на лекарствена резистентност бързо нарастват, представлявайки все по-голяма заплаха за общественото здраве. В рамките на пет години – от 2018 до 2023 г. – антибиотичната резистентност се е увеличила при над 40 процента от наблюдаваните антибиотици, с годишен среден ръст от 5 до 15 процента, установи доклад на Световната здравна организация (СЗО), публикуван в понеделник, предаде Politico.
Докладът за глобално наблюдение на антибиотичната резистентност проследява 22 ключови антибиотика, използвани за лечение на инфекции, причинени от осемте най-често срещани бактериални патогена, включително инфекции на пикочните пътища и гонорея.
Антимикробната резистентност (AMR) е една от най-големите заплахи за общественото здраве на 21-ви век и може значително да затрудни лечението на обикновени инфекции, според СЗО. Тя се причинява основно от прекомерната и неправилна употреба на лекарства, което позволява на патогените да станат резистентни, и се подхранва от лоша санитария и липса на чиста вода. Бактериалната AMR е причинила смъртта на 1,27 милиона души през 2019 г. и е допринесла за още 4,95 милиона смъртни случая през същата година.
The United Nations' health agency says the number of drug-resistant bacterial infections is surging, compromising life-saving treatments and rendering minor injuries and common infections potentially deadly. https://t.co/2j39z2AfD2
— CBS News (@CBSNews) October 13, 2025
„Антимикробната резистентност изпреварва напредъка на съвременната медицина, застрашавайки здравето на семействата по целия свят“, заяви Тедрос Адханом Гебрейесус, генерален директор на СЗО. „Докато страните укрепват своите системи за наблюдение на AMR, ние трябва да използваме антибиотиците отговорно и да гарантираме, че всеки има достъп до правилните лекарства, качествени диагностични средства и ваксини“, добави той.
Средното ниво на антибиотична резистентност в Европа е 10,2 процента, което е второто най-ниско ниво сред регионите и е под глобалната средна стойност от 17,2 процента.
Най-голямата заплаха идва от грам-отрицателните бактерии, които включват E. coli и K. pneumoniae, и са сред най-тежките бактериални инфекции. Над 40 процента от E. coli и 55 процента от K. pneumoniae в световен мащаб са резистентни към лечението от първа линия, установи докладът.
Latest @WHO Global Antibiotic Resistance Surveillance Report 2025 launched today cautions on 👉increasing resistance to essential antibiotics👈
— CNS (@cns_health) October 13, 2025
👉limited capacity to prevent, diagnose & treat infections → to higher #AMR 👈https://t.co/jPyvt9oMet#AntimicrobialResistance pic.twitter.com/nh5NBUMR0w
Други тревоги включват бактерията, причиняваща гонорея, която е развила резистентност към всички налични лекарства за първа линия на лечение. Едно лекарство, ципрофлоксацин, вече не е подходящо поради широко разпространената резистентност, докато друго, азитромицин, е изключено от рутинната терапия. Резистентността към азитромицин е най-висока в европейския регион, достигайки почти 26 процента.
Тъй като бактериите стават резистентни към антибиотиците от първа линия, лекарите все повече трябва да разчитат на лечения от последна инстанция, които са по-скъпи и по-трудни за достъп, особено в страни с ниски и средни доходи.
Разработването на нови антибиотици е спряно поради липсата на печеливш пазар и стимули за частните компании да инвестират в тях. Европейската комисия предложи „ваучер за ексклузивност“, за да стимулира компаниите, които разработват нови антибиотици, като част от своя фармацевтичен пакет. Европейският парламент също иска да въведе награди за влизане на пазара за нови лекарства и модел на абонаментно плащане на ЕС – предложения, които в момента са в процес на обсъждане за актуализиране на фармацевтичните правила на ЕС.
Други модели, като Глобалното партньорство за изследвания и развитие на антибиотици, се стремят да разработват нови антибиотици на некомерсиална основа.